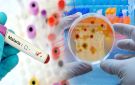

اخبار لبنان
موقع كل يوم -هنا لبنان
نشر بتاريخ: ٢٤ تشرين الأول ٢٠٢٥
أكدت رئيسة مصلحة الطب الوقائي في وزارة الصحة العامة، الدكتورة عاتكة بري، في حديثٍ لـ'هنا لبنان'، أنّ لبنان دائماً ما يسجّل حالات وافدة من مرض الملاريا، نتيجة وجود عدد كبير من المغتربين في البلدان التي ينتشر فيها المرض.
وأوضحت أنّه من حين إلى آخر تُسجّل حالات نادرة لم يثبت ارتباطها بالسفر، مشيرةً إلى أنّ الملاريا يمكن أن تنتقل عبر الدم وليس فقط عبر البعوض الناقل، لكنها لا تنتقل من شخص إلى آخر.
وشدّدت بري على أنّه ليس هناك أي انتشار محلّي للملاريا في لبنان، لافتةً إلى أنّه خلال فصل الصيف سُجّلت بضع حالات لم يثبت سفرها من أصل 234 حالة مرتبطة بالسفر، وهو رقم ضمن المعدلات السنوية المعتادة.
وأضافت أنّ فرق الوزارة المختصة أجرت فحوصات للمخالطين الذين تنطبق عليهم شروط الفحص وجاءت النتائج جميعها سلبية، كما تمّ أخذ عينات من البعوض في المناطق المعنية ولم يُثبت وجود البعوض الناقل للمرض.
وأشارت بري إلى أنّ الوزارة أصدرت تعميمًا تذكيريًا للمستشفيات بهدف رفع مستوى التوعية حول المرض وأهمية التشخيص المبكر، وهو إجراء وقائي معتاد عند تسجيل حالات غير مرتبطة بالسفر بشكل واضح.
وختمت مؤكدةً أنّ وزارة الصحة تتابع عن كثب الأمراض الانتقالية والمستجدة بالتعاون مع لجنة وطنية تضم أخصائيين من القطاعين العام والخاص، مشيرةً إلى أنّ بعض الحالات قد تنفي السفر رغم حصوله، ما يفسّر استخدام تعبير “لم يثبت سفرها”.
مواضيع مماثلة للكاتب: